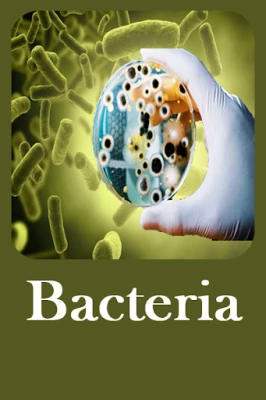

Latest Version
Version
1.6
1.6
Update
September 19, 2025
September 19, 2025
Developer
BhadarApps
BhadarApps
Categories
Internet
Internet
Platforms
Android
Android
Downloads
0
0
License
Free
Free
Package Name
com.bhadartech.bacteria
com.bhadartech.bacteria
Report
Report a Problem
Report a Problem
More About Bacteria - Infections and Type
App has a beautiful and simple interface. The best choice for a pocket dictionary that is always at hand. From this, you can learn a lot of new and interesting things.
Bacteria common noun bacteria, singular bacterium constitute a large domain of prokaryotic microorganisms. Typically a few micrometers in length, bacteria have a number of shapes, ranging from spheres to rods and spirals. Bacteria were among the first life forms to appear on Earth, and are present in most of its habitats. Bacteria inhabit soil, water, acidic hot springs, radioactive waste, and the deep portions of Earth's crust. Bacteria also live in symbiotic and parasitic relationships with plants and animals.
There are typically 40 million bacterial cells in a gram of soil and a million bacterial cells in a milliliter of freshwater. There are approximately 5×1030 bacteria on Earth, forming biomass that exceeds that of all plants and animals. Bacteria are vital in many stages of the nutrient cycle by recycling nutrients such as the fixation of nitrogen from the atmosphere. The nutrient cycle includes the decomposition of dead bodies and bacteria are responsible for the putrefaction stage in this process.
Bacteria are microscopic, single-celled organisms that thrive in diverse environments. These organisms can live in soil, the ocean, and inside the human gut.
You can find microbes everywhere they're extremely adaptable to conditions and survive wherever they are.
* Features:
- Contains over 4000 definitions of characteristics and terms;
- Ideal for professionals, students, and hobbyists alike.
- Advanced search function with autocomplete - search will start and predict word as you type.
- Work offline - database packaged with the app, no data costs incurred when searching.
- Includes hundreds of examples to illustrate the definitions.
🌼 Why Install This App?
To explore the world of bacteria and microorganisms in detail.
To quickly access scientific terms and explanations.
To use as a study companion for biology, microbiology, and life sciences.
To learn how microbes impact health, ecosystems, and industries.
To carry a reliable dictionary in your pocket for quick reference anytime.
🌍 What You’ll Learn:
Bacteria Basics: Shapes, sizes, and classification (spherical, rod-shaped, spiral).
Habitats: From soil, oceans, and hot springs to the human gut.
Roles in Nature: Decomposition, nutrient cycling, nitrogen fixation.
Human Connections: Beneficial bacteria, harmful bacteria, and antibiotics.
Microbiology Terms: Cell structures, symbiosis, parasitism, and more.
There are typically 40 million bacterial cells in a gram of soil and a million bacterial cells in a milliliter of freshwater. There are approximately 5×1030 bacteria on Earth, forming biomass that exceeds that of all plants and animals. Bacteria are vital in many stages of the nutrient cycle by recycling nutrients such as the fixation of nitrogen from the atmosphere. The nutrient cycle includes the decomposition of dead bodies and bacteria are responsible for the putrefaction stage in this process.
Bacteria are microscopic, single-celled organisms that thrive in diverse environments. These organisms can live in soil, the ocean, and inside the human gut.
You can find microbes everywhere they're extremely adaptable to conditions and survive wherever they are.
* Features:
- Contains over 4000 definitions of characteristics and terms;
- Ideal for professionals, students, and hobbyists alike.
- Advanced search function with autocomplete - search will start and predict word as you type.
- Work offline - database packaged with the app, no data costs incurred when searching.
- Includes hundreds of examples to illustrate the definitions.
🌼 Why Install This App?
To explore the world of bacteria and microorganisms in detail.
To quickly access scientific terms and explanations.
To use as a study companion for biology, microbiology, and life sciences.
To learn how microbes impact health, ecosystems, and industries.
To carry a reliable dictionary in your pocket for quick reference anytime.
🌍 What You’ll Learn:
Bacteria Basics: Shapes, sizes, and classification (spherical, rod-shaped, spiral).
Habitats: From soil, oceans, and hot springs to the human gut.
Roles in Nature: Decomposition, nutrient cycling, nitrogen fixation.
Human Connections: Beneficial bacteria, harmful bacteria, and antibiotics.
Microbiology Terms: Cell structures, symbiosis, parasitism, and more.
Rate the App
Add Comment & Review
User Reviews
Based on 0 reviews
No reviews added yet.
Comments will not be approved to be posted if they are SPAM, abusive, off-topic, use profanity, contain a personal attack, or promote hate of any kind.
More »










Popular Apps

Shape FoldBikas

GS Auto Nissan Connectikon Technologies

Adobe Acrobat Reader: Edit PDFAdobe

Forward: Escape The FoldChristophe Coyard

Messages - SMS Texting AppBattery Stats Saver

Bluetooth Volume Managerdarken

Action for Happiness: Get TipsAction for Happiness

ThreadsInstagram

Volume ManagerByteHamster

Discord - Talk, Play, Hang OutDiscord Inc.
More »










Editor's Choice

SigmaSigma Platform

Committees - AvenuesVladimir Semakov

Comma CommunityMighty Networks

Merge and HookKobGames

T-Mobile Scam ShieldT-Mobile USA

SaveMyTime - Time TrackerSave My Time

LED Banners - Text ScrollerAloha Std

HeavenBurnsRedYostar Limited.

Bingo HeavenAlitechnalogy

heaven travelyanSquareHeaven